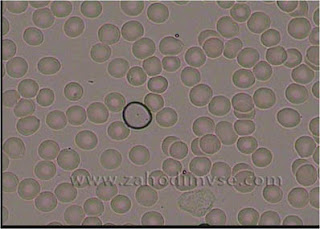

Кровь под микроскопом!!!
ДЫХАТЕЛЬНАЯ СИСТЕМА. ПРОФИЛАКТИКА: ОРЗ ОРВИ БРОНХИТ БРОНХИАЛЬНАЯ АСТМА ПНЕВМОНИЯ КАШЕЛЬ ОТЗЫВЫ
Дыхательная система
По данным Всемирной организации здравоохранения заболевания органов дыхания находится на первом месте в структуре заболеваемости, опередив даже сердечно-сосудистые.
Высок удельный вес как хронических (хронический бронхит, бронхиальная астма), так и острых (острый бронхит, пневмония) заболеваний. Огромное число людей болеют острыми респираторными вирусными заболеваниями по несколько раз в год.
От нормальной работы дыхательной системы зависит не только обеспечение каждой клетки, ткани кислородом и выделение углекислоты. Функции дыхательной системы разнообразны: поддержание оптимального теплового баланса, защита организма от неблагоприятных факторов окружающей среды, секреция ряда биологически активных веществ и т. д.
Причины нарушения нормального функционирования дыхательной системы
Не секрет, что воздух, которым мы дышим, содержит выбросы промышленных предприятий, выхлопные газы транспортных средств, пыль, обладающую токсическим и аллергизирующим действием, кроме того значительная часть населения добавляет себе и окружающим еще и канцерогенные смолы, содержащиеся в табачном дыме. Это приводит к тому, что легкие не справляются с выделением токсинов, как внутреннего, так и внешнего происхождения.
Неправильное и неполноценное питание приводит к недостатку в организме витаминов и минералов. В результате снижается активность иммунной системы, которая обеспечивает антибактериальную и антивирусную защиту организма.
Неблагоприятные природные факторы, эпидемии, плохая экология, стрессовые ситуации так же снижают иммунитет.
Обезвоживание организма резко снижает количество слизи, изменяет ее качество, затрудняя ее отхаркивание, способствует развитию аллергических реакций.
Внимание!Для улучшения качества определения причин плохого самочувствия — появилась уникальная возможность увидеть свою живую кровь при помощи визуального метода Гемосканирования на темнопольном микроскопе
Посмотрите фильм от том, что нужно делать для своего организма, во избежание любых проблем.
Механизмы восстановления функции дыхательной системы
Важным условием восстановления функции дыхания, как при острых, так и при хронических заболеваниях, является снятие болевых ощущений и спазмов. Необходимо стимулировать приток крови больному органу одновременно очищая его, обеспечить выделение мокроты из дыхательных путей и облегчить дыхание.
Механизмы восстановления функции дыхательной системы
Важным условием восстановления функции дыхания, как при острых, так и при хронических заболеваниях, является снятие болевых ощущений и спазмов. Необходимо стимулировать приток крови больному органу одновременно очищая его, обеспечить выделение мокроты из дыхательных путей и облегчить дыхание.
Набор трав №3 — эффективно справляется с данной задачей. Содержит в своем составе тимьян, листья коровяка, эриодикт калифорнийский, листья окопника, цветки красного клевера и семена пажитника греческого.
Способ применения:по 1 таблетке 2 раза в день, можно растворить в 1 стакане воды и пить как чай.
Корень солодки — оказывает иммуномодулирующий и тонизирующий эффект, что блоготворно влияет на функцию бронхов. Препарат обладает противовоспалитьльным и антиаллергическим действием.
Способ применения:растворить 1 табл. в 1 стакане воды и пить как чай 3 раза в день.
Кора муравьиного дерева — известно очень давно его противовирусное действие. Еще древние инки использовали кору, как лекарственное средство.
Способ применения: по 1 капсуле 3 раза в день после еды.
Лакс-макс —один из самых универсальных антибактериальных препаратов широкого спектра действия. Препарат воздействует на все известные микроорганизмы. Кроме того, в отличие от химических антибиотиков, не уничтожает микрофлору кишечника.
Способ применения: по консультации врача.
[Очанка Процесс выздоровления идет значительно быстрее, если в организм поступает достаточное количество витаминов и микроэлементов. ОЧАНКА богата витаминами А, С, группы В, содержит много кремния и железа. Она стимулирует иммунитет и улучшает качество крови.
Способ применения: по 1 таблетке 3 раза в день.
Чеснок — как натуральный антибиотик, издавна применялся для лечения и профилактики заболеваний органов дыхания. Препараты Чеснока содержат большое количество витаминов, а также эфирных масел, фитонцидов и йода. Он способствует нейтрализации анцерогенов в условиях неблагоприятной экологической обстановки, а также улучшает работу желудочно-кишечного тракта и способствует восстановлению иммунитета.
Способ применения:по 1 таблетке 2 раза в день, можно растворить в 1 стакане воды и пить как чай.
Корень солодки — оказывает иммуномодулирующий и тонизирующий эффект, что блоготворно влияет на функцию бронхов. Препарат обладает противовоспалитьльным и антиаллергическим действием.
Способ применения:растворить 1 табл. в 1 стакане воды и пить как чай 3 раза в день.
Кора муравьиного дерева — известно очень давно его противовирусное действие. Еще древние инки использовали кору, как лекарственное средство.
Способ применения: по 1 капсуле 3 раза в день после еды.
Лакс-макс —один из самых универсальных антибактериальных препаратов широкого спектра действия. Препарат воздействует на все известные микроорганизмы. Кроме того, в отличие от химических антибиотиков, не уничтожает микрофлору кишечника.
Способ применения: по консультации врача.
[Очанка Процесс выздоровления идет значительно быстрее, если в организм поступает достаточное количество витаминов и микроэлементов. ОЧАНКА богата витаминами А, С, группы В, содержит много кремния и железа. Она стимулирует иммунитет и улучшает качество крови.
Способ применения: по 1 таблетке 3 раза в день.
Чеснок — как натуральный антибиотик, издавна применялся для лечения и профилактики заболеваний органов дыхания. Препараты Чеснока содержат большое количество витаминов, а также эфирных масел, фитонцидов и йода. Он способствует нейтрализации анцерогенов в условиях неблагоприятной экологической обстановки, а также улучшает работу желудочно-кишечного тракта и способствует восстановлению иммунитета.
Способ применения: по 1 капсуле 2 раза в день во время еды.
Алка-Майн, Коралловая вода — это биологически активная вода с ощелачивающими минералами, повышает эффективность применения программы, т. к. необходимо поддерживать в организме оптимальный баланс водных запасов, отдавая предпочтение чистой биологически доступной воде.
Она обладает улучшенными биологическими свойствами (пониженным поверхностным натяжением, слабо щелочной реакцией рН), соответствующими потребностям клеток организма. Вода имеет упорядоченную структуру атомов, обогащена минералами и, к тому же, вкусная.
Способ применения: 1 пакетик на 1,5литра воды.

Комментариев нет:
Отправить комментарий